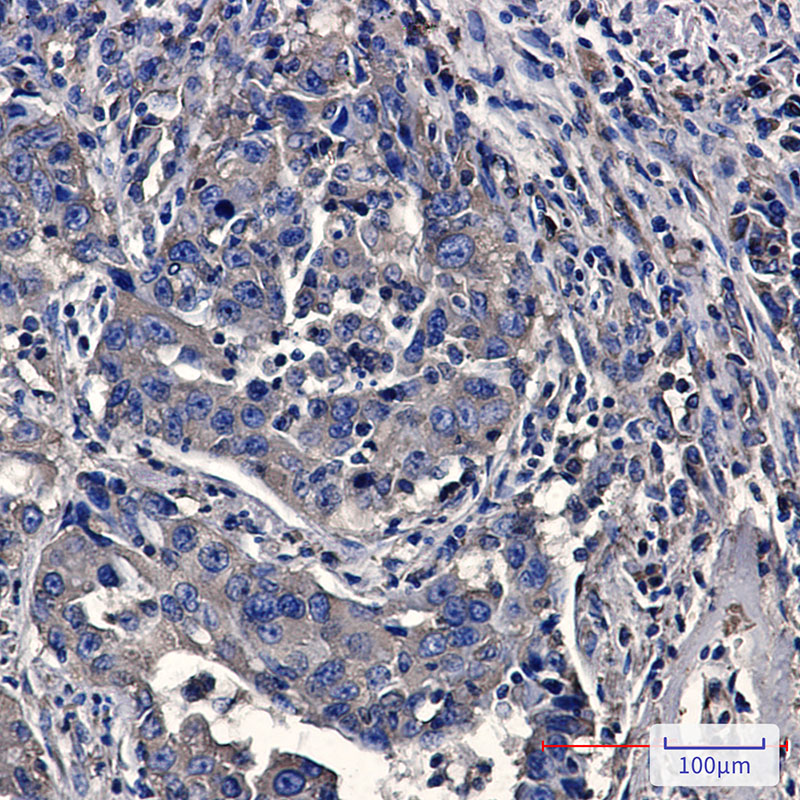

-
分类: 科研抗体货号: P22449别名: MCM4; CDC21; DNA replication licensing factor MCM4; CDC21 homolog; P1-CDC21应用: WB,IP反应种属: Human
-
分类: 科研抗体货号: P22448别名: MCM2; BM28; CCNL1; CDCL1; KIAA0030; DNA replication licensing factor MCM2; Minichromosome maintenance protein 2 homolog; Nuclear protein BM28应用: WB,IP,IHC,IF反应种属: Human
-
分类: 科研抗体货号: P22464别名: NS11; M-RAs; RRAS3; R-RAS3应用: WB,IP反应种属: Human,Mouse,Rat
-
分类: 科研抗体货号: P22447别名: KIF2C; KNSL6; Kinesin-like protein KIF2C; Kinesin-like protein 6; Mitotic centromere-associated kinesin; MCAK应用: WB,IF反应种属: Human
-
分类: 科研抗体货号: P22482别名: ACH4; AChR; Acra4; BFNC; CHRNA4; EBN; EBN1; NACHR; NACRA4应用: WB,IP反应种属: Human,Mouse,Rat,Hamster
-
分类: 科研抗体货号: P22463别名: MRG1; PEMP; AAG12; EMP55; DXS552E应用: WB反应种属: Human
-
分类: 科研抗体货号: P22475别名: NADH dehydrogenase (ubiquinone) Fe-S protein 2; 49kDa; CI-49应用: WB,IP,IHC反应种属: Human
-
分类: 科研抗体货号: P22481别名: NgR3; NGRH2应用: WB,IF反应种属: Human,Mouse,Rat
-
分类: 科研抗体货号: P22462别名: MSN; Moesin; Membrane-organizing extension spike protein; RDX; Radixin; EZR; VIL2; Ezrin; Cytovillin; Villin-2; p81应用: WB,IP,IHC,IF反应种属: Human,Mouse,Rat
-
分类: 科研抗体货号: P22474别名: NDUFS1; NADH-ubiquinone oxidoreductase 75 kDa subunit; mitochondrial; Complex I-75kD; CI-75kD应用: WB,IP,IHC,IF反应种属: Human,Mouse,Rat

鄂公网安备42018502007531号
鄂公网安备42018502007531号

